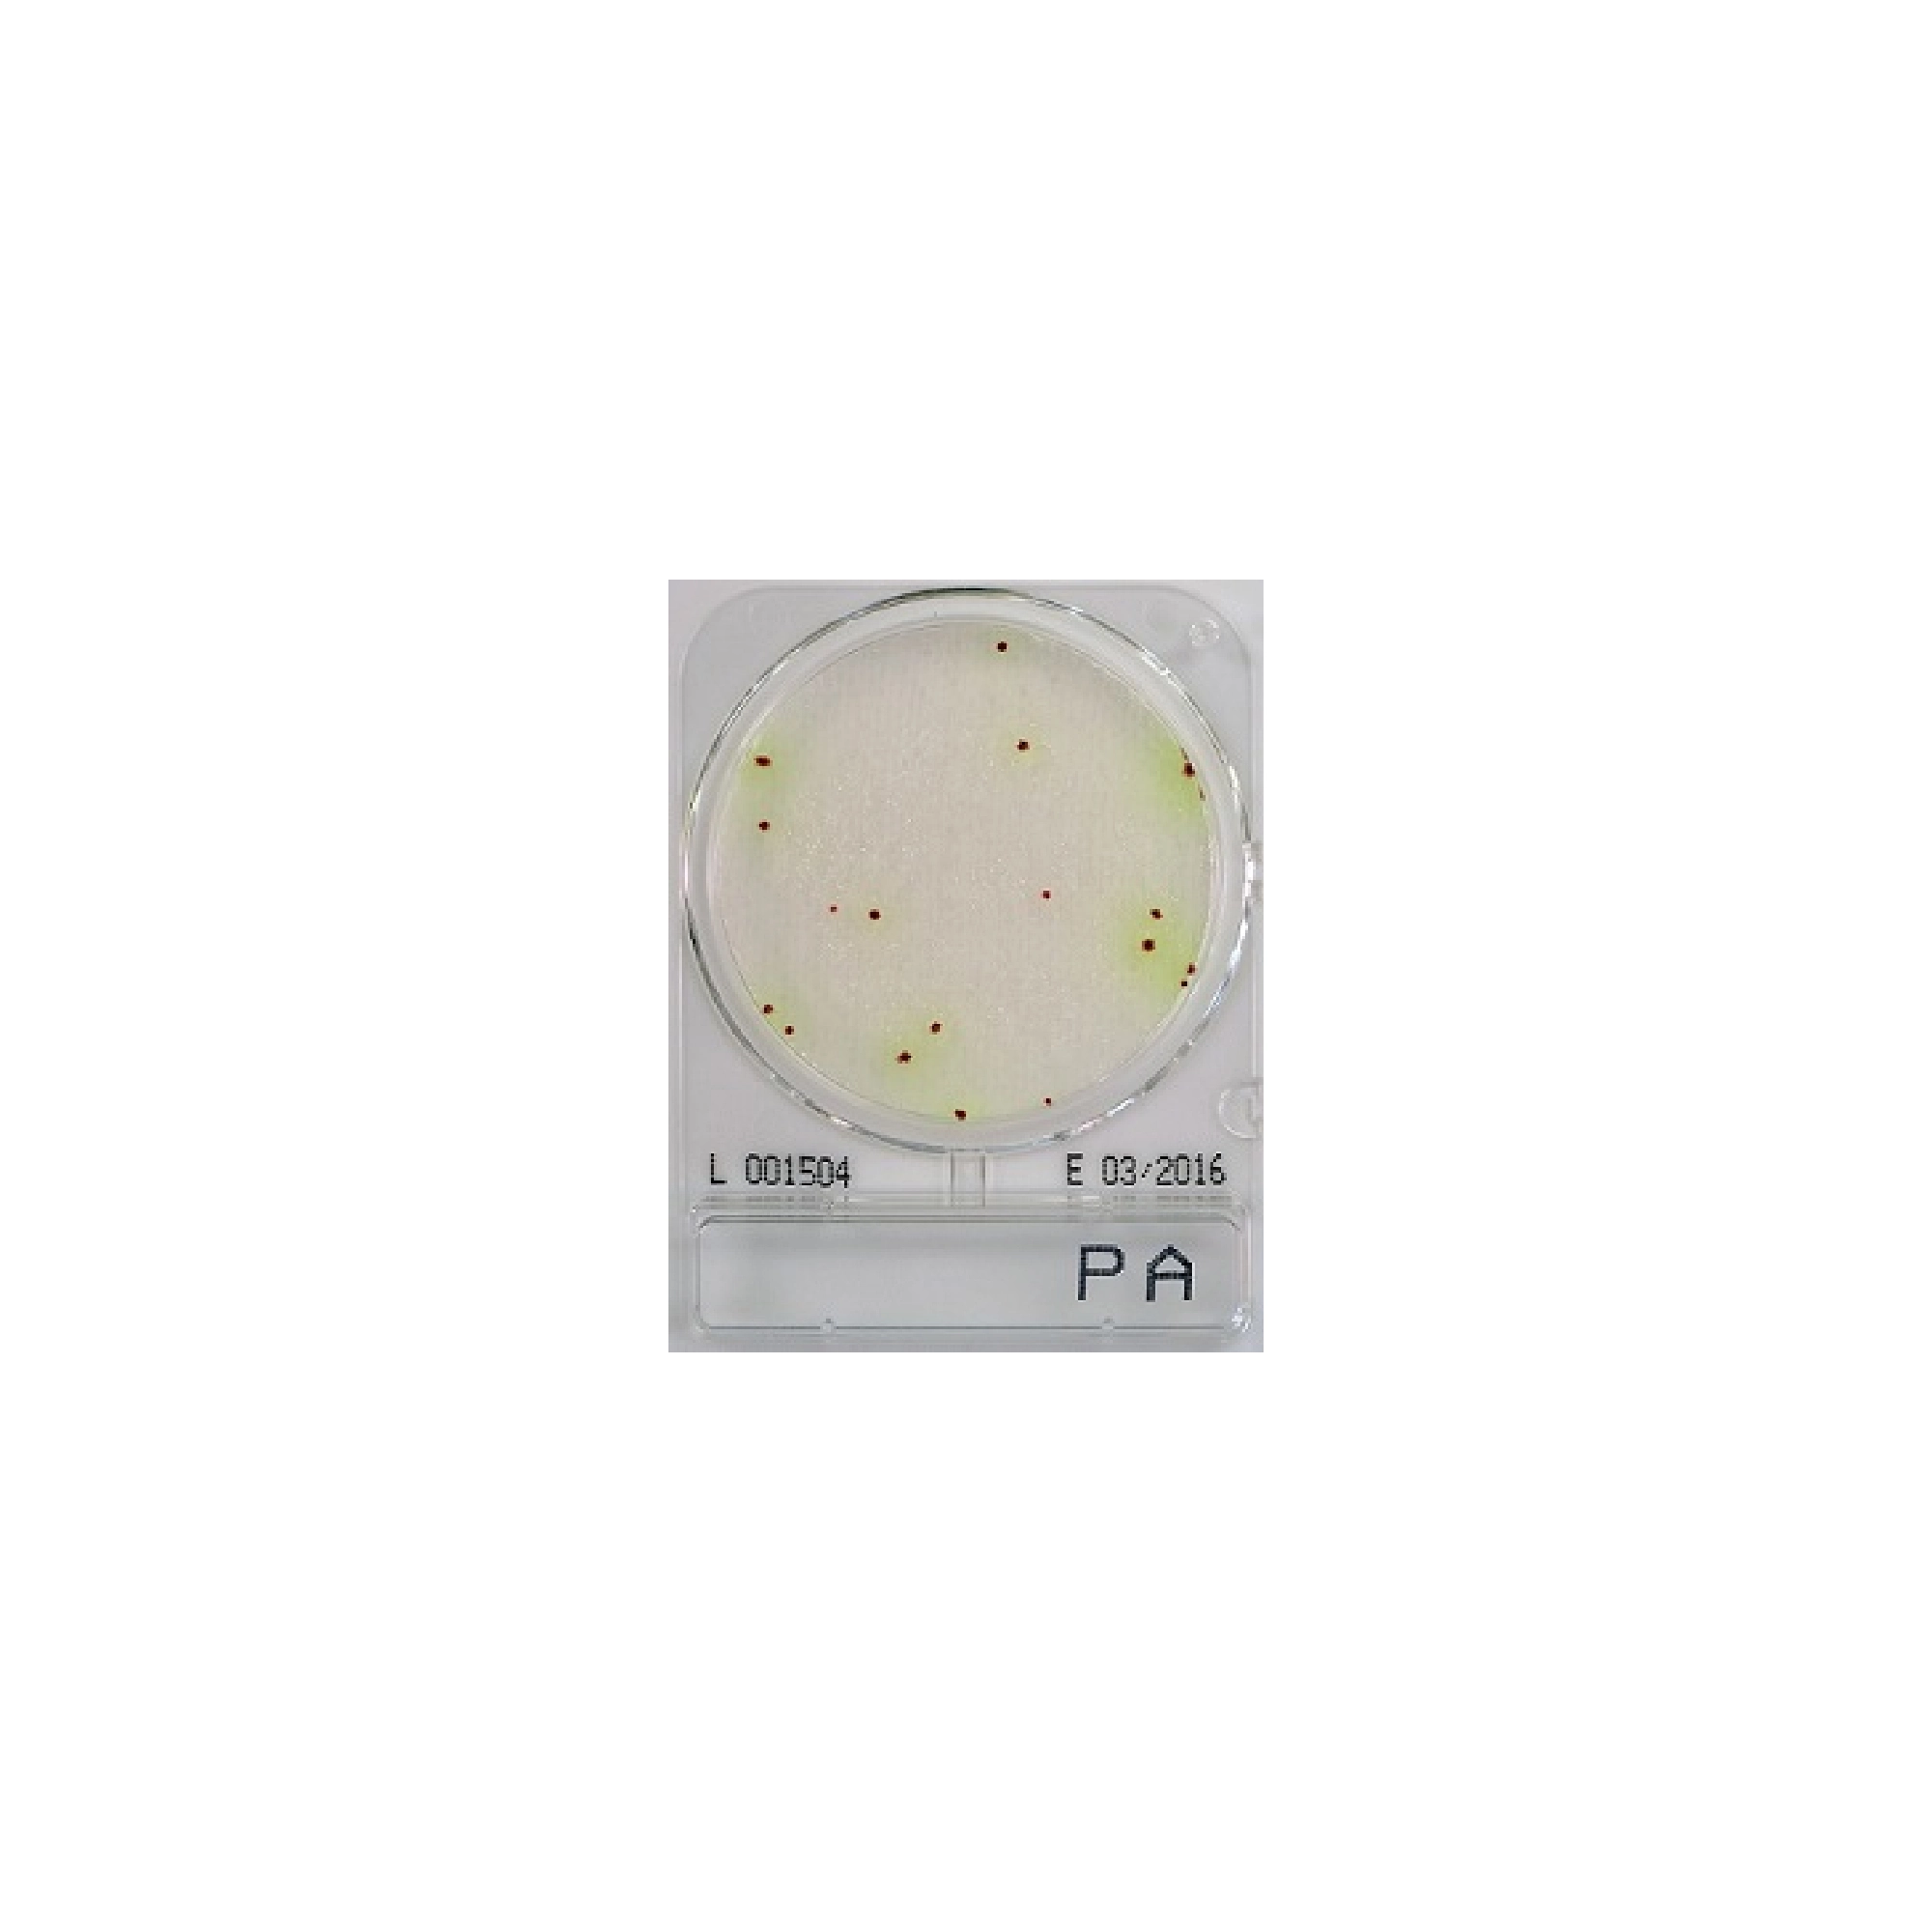
Compact Dry PA - pseudomonas aerugionsa viszgálatához

Sütik? Valószínűleg már hallottál róluk. Ezek apró szöveges fájlok, amelyek a weboldalra történő belépéskor elmentik a beállításaidat és preferenciáidat. Azért használjuk őket, hogy javítsuk a felhasználói élményt és személyre szabott tartalmakat nyújtsunk. Egyes sütik elengedhetetlenek, mivel biztosítják az oldal alapvető működését. Minden szakaszban eldöntheted, hogy mely sütik engedélyezését szeretnéd.
Az Alphaportal oldalon használt sütik az alábbiakban nyújtanak segítséget:
Az adatvédelemről, adatkezelésről bővebben az Adatkezelési Tájékoztatóban olvashatsz.
Funkció: Ez a beállítás lehetővé teszi a webhely számára, hogy olyan adatokat tároljon, amelyek a hirdetések megjelenítéséhez és optimalizálásához szükségesek, például cookie-kat vagy eszközazonosítókat. Ezek az információk segítik a hirdetési rendszereket abban, hogy a felhasználók számára releváns tartalmakat jelenítsenek meg.
Miért érdemes engedélyezni: Az engedélyezés révén a megjelenő reklámok jobban igazodnak az érdeklődési körödhöz, így elkerülheted az irreleváns, vagy ismétlődő hirdetéseket. Ez nemcsak hatékonyabbá teszi a hirdetéseket, hanem kényelmesebbé és gördülékenyebbé a böngészést is. Tiltás esetén is megjelennek a reklámok (például a közösségi oldalakon), csak azok nem igazodnak az érdeklődési körödhöz.
Funkció: Ez a beállítás lehetővé teszi a webhely számára, hogy gyűjtse és tárolja az olyan analitikai adatokat, mint például a látogatások időtartama, a gyakran látogatott oldalak vagy a felhasználók által végzett interakciók. Ezek az adatok segítik a webhely üzemeltetőit abban, hogy átfogó képet kapjanak a látogatók viselkedéséről, az weboldal használatáról.
Miért érdemes engedélyezni: Az ilyen információk elemzése segít a weboldal üzemeltetőinek azonosítani, hogy mi működik jól és mit érdemes fejleszteni. Ennek eredményeként a tartalmak és a funkciók még inkább igazodhatnak a felhasználói igényekhez, ami gyorsabb, kényelmesebb és hatékonyabb felhasználói élményt biztosít.
Funkció: Ez a beállítás lehetővé teszi, hogy a webhely továbbítsa a Google számára azokat a hirdetésekkel kapcsolatos adatokat, amelyek konkrétan a felhasználóhoz köthetők, például felhasználói azonosítókat vagy a felhasználó által megadott információkat. Ezek az adatok kulcsfontosságúak a hirdetési kampányok hatékonyságának mérésében és a célzás javításában.
Miért érdemes engedélyezni: Az engedélyezéssel a webhely és a hirdetési rendszerek pontosabban tudják értékelni, hogy a hirdetések mennyire érik el céljukat, és ez alapján finomítani tudják azokat. Ennek eredményeként a megjelenő reklámok jobban igazodnak az érdeklődési körödhöz, így relevánsabb és hasznosabb tartalmakat kapsz, miközben elkerülheted az irreleváns hirdetéseket.
Funkció: Ez a beállítás lehetővé teszi, hogy a hirdetési rendszerek a felhasználó érdeklődési köre, online viselkedése vagy korábbi tevékenységei alapján személyre szabott hirdetéseket jelenítsenek meg.
Miért érdemes engedélyezni: A személyre szabott hirdetések sokkal relevánsabbak a felhasználók számára, hiszen olyan termékeket, szolgáltatásokat vagy tartalmakat ajánlanak, amelyek valóban érdekelhetik őket. Ez nemcsak érdekesebbé teszi a böngészési élményt, hanem segít elkerülni a zavaró, irreleváns vagy ismétlődő hirdetéseket, így gördülékenyebb és élvezetesebb online élményt biztosít.
Funkció: Ez a beállítás lehetővé teszi a webhely számára, hogy olyan alapvető adatokat tároljon, amelyek a webhely vagy alkalmazás zavartalan működéséhez szükségesek, például a nyelvi beállításokat, a kosár tartalmát vagy más, a felhasználói élményt támogató információkat.
Információ: Az engedélyezéssel a webhely képes emlékezni a preferenciáidra, például arra, hogy milyen nyelvet választottál, vagy milyen termékeket tettél a kosárba. Ez garantálja, hogy a böngészés folyamatos, kényelmes és személyre szabott legyen, anélkül hogy minden alkalommal újra be kellene állítanod ezeket az adatokat.
Funkció: Ez a beállítás lehetővé teszi a webhely számára, hogy tárolja a személyre szabással kapcsolatos adatokat, például a korábbi tevékenységek alapján készült videó- vagy tartalomajánlásokat. Ezek az információk segítenek abban, hogy a felhasználó egyedi igényeire szabott tartalmak jelenjenek meg.
Miért érdemes engedélyezni: Az engedélyezéssel a webhely képes relevánsabb, az érdeklődési körödhöz igazított tartalmakat kínálni. Ez nemcsak élvezetesebbé teszi a böngészést, hanem időt is megtakarít, hiszen nem kell keresgélned azokat az információkat vagy ajánlásokat, amelyek valóban érdekesek számodra.
Funkció: Ez a beállítás lehetővé teszi a webhely számára, hogy olyan adatokat tároljon, amelyek a biztonságos működéshez szükségesek. Ilyenek például a hitelesítési adatok, a csalásmegelőzéshez használt információk, vagy a felhasználói adatok védelmét szolgáló intézkedések.
Információ: Az engedélyezés garantálja a webhely és a felhasználói adatok biztonságát. Ezáltal elkerülhetőek a jogosulatlan hozzáférések, csökkenthetőek a csalások, és biztosítható a zavartalan és biztonságos böngészési élmény. Az ilyen típusú tárolás az adatvédelem alapvető feltétele, amely mind a felhasználók, mind a webhely működésének érdekeit szolgálja.